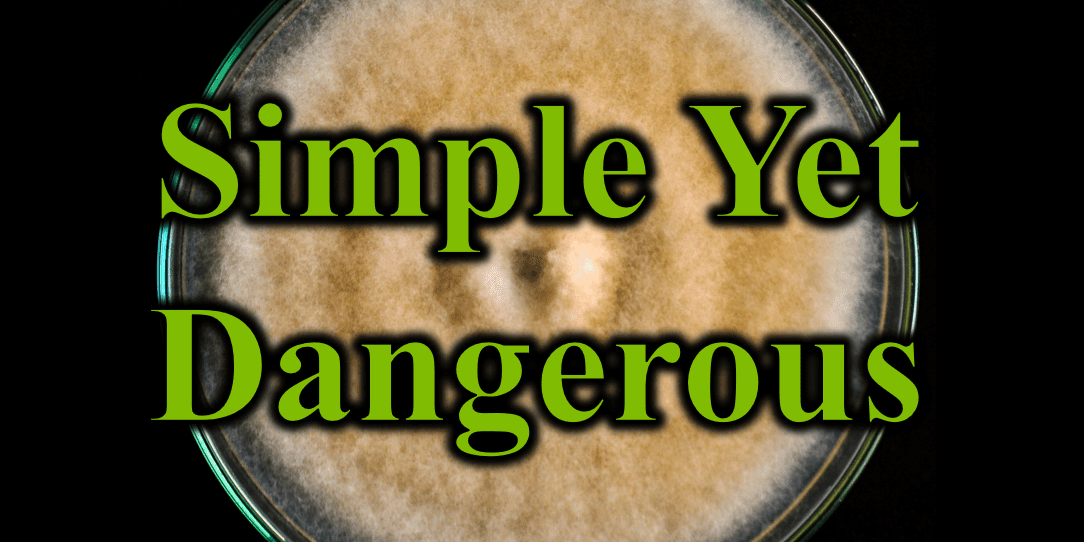
Simple Yet Dangerous

Mold is everywhere, so they say. “They” refers to mainstream medicine as they try to convince you that mold toxicity cannot be causing your symptoms. They challenge you to explain how a little chemical called a mycotoxin made by little molds that are all around us could somehow make you feel as horrible as you do. They would often rather blame your mental health and send you to a psychiatrist. You may begin to doubt yourself and doubt your functional medicine provider like myself who is urging you to detox and get mold out of your home. As my business coach would say, “Step back and gain some perspective.” In this case, look at the research evidence for mold toxicity and consider the fact that we have seen countless others with similar symptoms recover through mold detox. Over the coming weeks, I will share some of the research evidence so you can decide for yourself.
Deoxynivalenol (DON), a trichothecene mycotoxin produced by fungus including Fusarium species, occasionally shows up on urinary mycotoxin testing in mold toxic patients. Like other trichothecene mycotoxins, they may have acute toxic effects when contacting the skin or intestinal mucosa (1). Chronic exposure has been linked to immune suppression, teratogenicity, cardiac toxicity, GI inflammation, slower weight gain, and feeding problems in animals (2,3,4), but studies in humans have not linked it with cancer potential (5). In outbreaks of toxicity, individuals reported fever, headaches, diarrhea, dizziness, abdominal pain, nausea, and vomiting, often with rapid onset after acute exposure (3).
The mechanism of deoxynivalenol’s toxicity appear related to a chemical structure in it, called an epoxide and requires no metabolic processing in humans to exerts its adverse effects. Even low-level exposure in animals has been found to modify levels of various chemokines and cytokines of the immune system, the chemical messengers used to turn up or down or direct our immune defenses (6,7). This appears to occur through effects on which genes of our cells are turned on to produce these immune messengers. The toxin also appears to modify “mitogen-activated protein kinase (MAPK)-controlled physiological processes, including processes controlling cell apoptosis, cell differentiation, and cell growth, all of which are crucial for the immune response’s signal transduction. (8,7).” In other studies, the toxin appears to impair growth hormone production in mice secondary to these cytokine changes (2).
The primary reference paper providing this information focuses attention on this toxin coming from Fusarium species growing on various types of grains, like wheat or beans, and some spices. While this is a potential source for human intoxication, monitoring of the food supply makes this less likely in developed countries although still problematic in undeveloped countries without such monitoring. In reality, other studies listed in the secondary bibliography reference the prevalence of Fusarium growth in indoor environments with their potential to negatively affect human health (9, 10, 11). Several remediator or mold testing websites referenced below also note the potential for Fusarium to grow on moist indoor building materials (Mold Adviser, Mold and Bacteria Consulting Laboratories, ServiceMaster). The journal articles describe how Fusarium may start outside one’s home, but spores entering the home can find hospitable areas for growth in locations like sinks and drains where higher moisture levels are found. While many toxic mold species prefer low humidity, Fusarium stands out as one of the few that flourishes in these wetter locations.
When seeing this toxin on a patient’s urinary report, we therefore have to consider both dietary and environmental factors. Farmers or those who work in some grain industry may experience occupational exposures through inhalation of grain dust. Those who store and eat particular grains at a future date may experience toxicity if the storage process permits Fusarium growth. Those who have a rarely used bathroom shower or sink may have some Fusarium growing happily in the drains since they are not getting flushed out by daily use. Then you can just have this mold growing where a continual supply of water keeps building materials like drywall or carpet more damp on a continual basis. In each of these cases, the active mold produces toxins that can be inhaled and accumulated in body tissues over time, resulting in toxicities.
Helping patients restore healthier more abundant lives requires not only identifying the root cause of their illness but also guiding them in removing the toxic sources from their lives. Without such diligence directed at a clear target, broad detox attempts usually fail to reach full recovery. Come back in future posts to learn more about other mycotoxins or read prior posts about mold toxicity on our site.
Bibliography
Awuchi CG, Ondari EN, Nwozo S, Odongo GA, Eseoghene IJ, Twinomuhwezi H, Ogbonna CU, Upadhyay AK, Adeleye AO, Okpala COR. Mycotoxins’ Toxicological Mechanisms Involving Humans, Livestock and Their Associated Health Concerns: A Review. Toxins (Basel). 2022 Feb 24;14(3):167. doi: 10.3390/toxins14030167. PMID: 35324664; PMCID: PMC8949390.
Secondary Bibliography:
- WHO Mycotoxins. 2018. [(accessed on 3 May 2021)]. Available online: https://www.who.int/news-room/fact-sheets/detail/mycotoxins
- Amuzie C.J., Pestka J.J. Suppression of insulin-like growth factor acid-labile subunit expression–a novel mechanism for deoxynivalenol-induced growth retardation. Toxicol. Sci. 2010;113:412–421. doi: 10.1093/toxsci/kfp225.
- Pestka J.J., Smolinski A.T. Deoxynivalenol: Toxicology and potential effects on humans. J. Toxicol. Environ. Health B Crit. Rev. 2005;8:39–69. doi: 10.1080/10937400590889458.
- Gray J.S., Pestka J.J. Transcriptional regulation of deoxynivalenol-induced IL-8 expression in human monocytes. Toxicol. Sci. 2007;99:502–511. doi: 10.1093/toxsci/kfm182.
- WHO . Safety Evaluation of Certain Contaminants in Food: Prepared by the Seventy-Second Meeting of the Joint FAO/WHO Expert Committee on Food Additives (JECFA) World Health Organization; Geneva, Switzerland: 2011. (WHO Food Additives Series, No. 63).
- Oufensou S., Dessì A., Dallocchio R., Balmas V., Azara E., Carta P., Migheli Q., Delogu G. Molecular Docking and Comparative Inhibitory Efficacy of Naturally Occurring Compounds on Vegetative Growth and Deoxynivalenol Biosynthesis in Fusarium culmorum. Toxins. 2021;13:759. doi: 10.3390/toxins13110759.
- Pestka J.J. Mechanisms of deoxynivalenol-induced gene expression and apoptosis. Food Addit. Contam. Part A Chem. Anal. Control Expo. Risk Assess. 2008;25:1128–1140. doi: 10.1080/02652030802056626.
- Awuchi C.G., Ondari E.N., Ogbonna C.U., Upadhyay A.K., Baran K., Okpala C.O.R., Korzeniowska M., Guiné R.P.F. Mycotoxins Affecting Animals, Foods, Humans and Plants: Types, Occurrence, Toxicities, Action Mechanisms, Prevention and Detoxification Strategies—A Revisit. Foods. 2021;10:1279. doi: 10.3390/foods10061279.
- Almatawah, Q. A., Al-Rashidi, M. S., Yassin, M. F., & Varghese, J. S. (2022). Microbiological contamination of indoor and outdoor environments in a desert climate. Environmental monitoring and assessment, 194(5), 355. https://doi.org/10.1007/s10661-022-10032-9.
- Kumar, P., Singh, A. B., & Singh, R. (2022). Comprehensive health risk assessment of microbial indoor air quality in microenvironments. PloS one, 17(2), e0264226. https://doi.org/10.1371/journal.pone.0264226.
- Adams, R. I., Miletto, M., Taylor, J. W., & Bruns, T. D. (2013). The diversity and distribution of fungi on residential surfaces. PloS one, 8(11), e78866. https://doi.org/10.1371/journal.pone.0078866
Remediator Sites:
Mold Advisor: https://www.mold-advisor.com/fusarium-mold.html
Mold and Bacteria Consulting Laboratories: https://www.moldbacteria.com/mold/fusarium.html#:~:text=In%20indoor%20environments%20Fusarium%20species,water%20occurs%20in%20HVAC%20systems.
ServiceMaster: https://www.servicemastersanfrancisco.com/what-is-fusarium-mold-and-where-is-it-found/
Sanctuary Functional Medicine, under the direction of Dr Eric Potter, IFMCP MD, provides functional medicine services to Nashville, Middle Tennessee and beyond. We frequently treat patients from Kentucky, Alabama, Mississippi, Georgia, Ohio, Indiana, and more... offering the hope of healthier more abundant lives to those with chronic illness.

Dr. Eric Potter graduated from Vanderbilt Medical School and then went on to specialize in internal medicine (adult) and pediatric care, spending significant time and effort in growing his medical understanding while caring for patients from all walks of life.